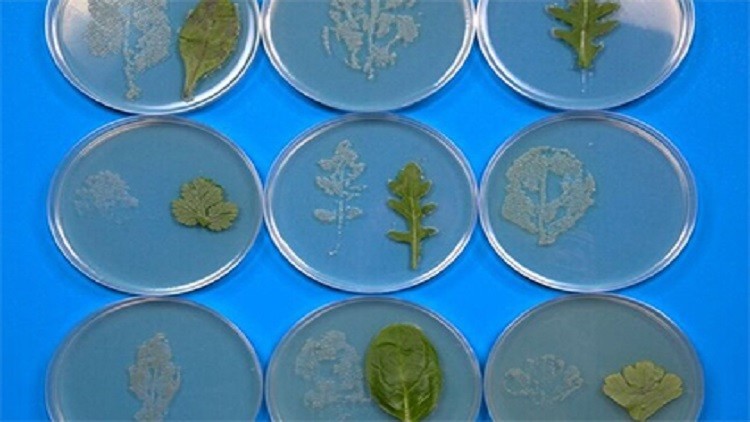
احذروا تناول الخضار المحفوظة في أكياس بلاستيكية

أكد علماء بريطانيون أن تناول الخس المبرد المحفوظ في أكياس بلاستيكية يشكل خطرا كبيرا على صحة الإنسان.
وخلال الأبحاث التي أجراها هؤلاء العلماء لاحظوا أن تخزين أوراق الخس في أكياس بلاستيكية، يزيد من تكاثر بكتيريا السالمونيلا Salmonella enterica على تلك الأوراق (بنسبة الضعف). فبعد فحص الخس المخزن لمدة 5 أيام ضمن أكياس بلاستيكية في البرادات، تبين أن أعداد البكتيريا على أوراق تلك النباتات بلغت حوالي 100 ألف نوع مختلف من بكتريا السالمونيلا، وفقا لـ "روسيا اليوم".
وأكد العلماء أن أغشية تلك الأنواع من السالمونيلا تظهر مقاومة شديدة للأدوية المخصصة لمحاربة البكتيريا.
وأشاروا إلى أن السالمونيلا تنتقل إلى أوراق الخس عن طريق التربة، وتظهر في التربة بداية بسبب الحشرات والطيور والأسمدة العضوية، كما يمكن أن تنقلها مياه الصرف الصحي.
وأظهرت التجارب أن السالمونيلا يمكن أن تدخل إلى الأوعية الداخلية في أوراق الخس حيث يصبح من المستحيل إزالتها من داخل تلك الأوراق، كما يمكن لتلك البكتيريا أن تتكاثر على أوراق العديد من الخضار المحفوظة في الأكياس البلاستيكية.